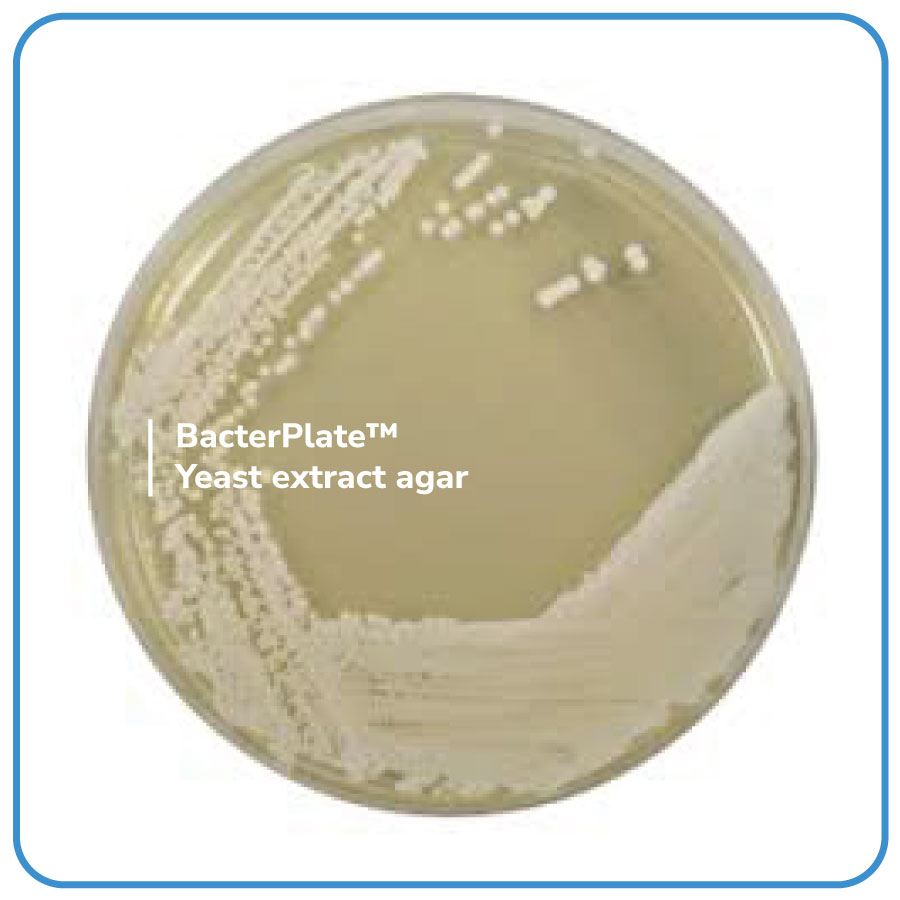

BacterPlate™ Yeast extract agar
Mã: 4102028
Mã đặt hàng/sản phẩm: 4102028
Số lượng tối thiểu: 1
BacterPlate™ Yeast extract agar ược sử dụng trong vi sinh vật học nước để định lượng vi sinh vật có thể nuôi cấy bằng cách đếm khuẩn lạc ở 36 và 22°C. Phương pháp này nhằm mục đích đo lường hiệu quả xử lý nước uống, và nói chung là tất cả các loại nước. Phương pháp này đặc biệt phù hợp để phân tích nước dùng cho con người, bao gồm nước đóng chai, nước khoáng thiên nhiên và nước hồ bơi.
- Thành phần: Tryptone; Yeast extract; Agar.
- pH của môi trường hoàn chỉnh ở 25°C: 7,2 ± 0,2.
- Quy cách: 10 đĩa/ hộp hoặc theo yêu cầu của khách hàng.
- Bảo quản lưu trữ: 2 - 8°C.
- Vận chuyển: Nhiệt độ môi trường.
- Hạn sử dụng: 04 tháng kể từ ngày sản xuất.
Danh sách đặt hàng
BacterPlate™ Yeast extract agar
Mã: 4102028
Đơn vị: Đĩa
| Tên sản phẩm | Hình ảnh | Mã đặt hàng/sản phẩm | Đơn vị tính | Số lượng | Chọn vào giỏ hàng |
|---|---|---|---|---|---|
| BacterPlate™ Yeast extract agar | ![]() | 4102028 | Đĩa |
